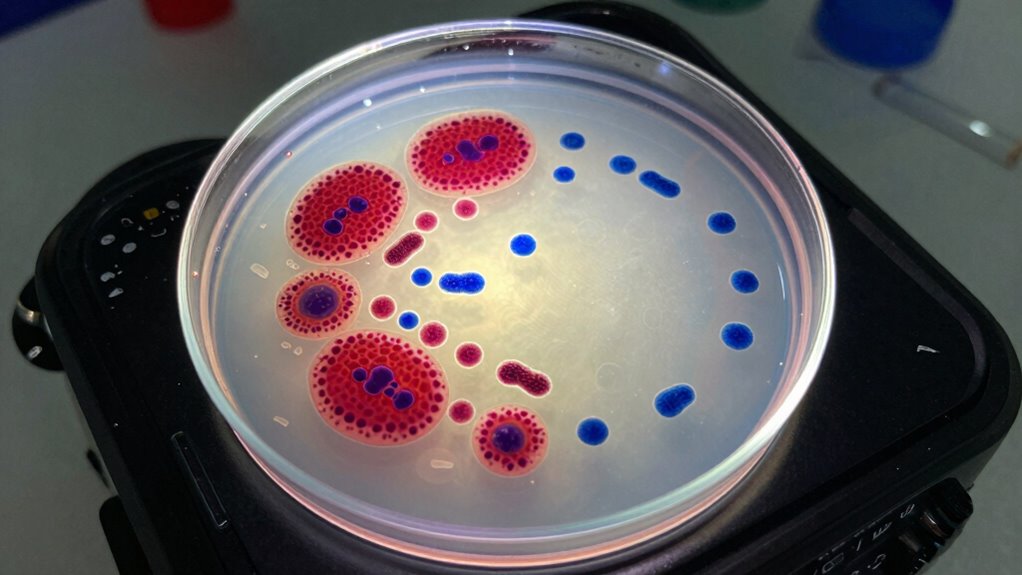
water testing for bacteria

Bacteria tests, like those for coliforms and E. coli, help you identify fecal contamination in water. If coliforms are present, it suggests possible contamination, while E. coli indicates recent fecal exposure and higher health risks. Proper testing involves collecting samples, following strict protocols, and using specialized lab methods. If bacteria are found, you should follow local guidelines, such as boiling water or switching to bottled water. For detailed steps, keep exploring how these tests work.
Key Takeaways
- Testing for coliforms and E. coli detects fecal contamination, indicating potential health risks in water sources.
- Laboratory methods like membrane filtration identify small bacterial quantities, confirming contamination presence.
- Detecting E. coli suggests recent fecal pollution, prompting immediate water safety measures.
- Positive results require following public health guidance, such as boiling water or using bottled supplies.
- Regular testing and swift response are essential to prevent waterborne diseases and ensure community safety.
Have you ever wondered how scientists detect harmful bacteria in food, water, or the environment? It’s a fascinating process that involves a series of careful steps known as testing procedures. When it comes to water contamination, these procedures are especially important because water can carry dangerous bacteria like coliforms and E. coli, which pose serious health risks. Testing begins by collecting water samples from the suspected source. These samples are handled with strict protocols to prevent contamination and guarantee accuracy. Once collected, the samples are transported to a laboratory where specialized methods are used to identify the presence of bacteria.
Water testing detects harmful bacteria like coliforms and E. coli to prevent health risks.
In the lab, the testing procedures typically involve growing bacteria from the water sample on selective media that encourage their growth while inhibiting others. For coliform bacteria, scientists use a method called membrane filtration or multiple-tube fermentation. These techniques allow them to detect even tiny amounts of bacteria in large water samples. If coliforms are found, it indicates that the water has been contaminated by fecal matter, which can harbor more dangerous pathogens like E. coli. The detection of E. coli, specifically, is more concerning because it directly signifies recent fecal contamination and potential health risks. To confirm E. coli presence, scientists often use more specific tests, such as enzyme substrate tests, that identify its unique biochemical properties.
Throughout these testing procedures, accuracy and safety are paramount. If bacteria are detected, authorities typically issue warnings or boil-water advisories to protect public health. The results also guide actions like water treatment or remediation efforts to eliminate contamination sources. It is also important to understand that these testing methods are continually evolving to improve detection accuracy and ensure public safety. If bacteria are detected, authorities typically issue warnings or boil-water advisories to protect public health. The results also guide actions like water treatment or remediation efforts to eliminate contamination sources. It’s vital to understand that these tests are not just about confirming contamination but also about preventing outbreaks of waterborne diseases. Regular testing and swift responses can make a big difference in safeguarding communities.
Knowing what to do next depends on the test outcomes. If harmful bacteria are found, you should follow local health guidelines, which usually include boiling water before use or using bottled water until the issue is resolved. For environmental or food-related concerns, authorities might investigate the source of contamination and implement measures such as improved sanitation or infrastructure upgrades. In brief, water testing procedures are an essential line of defense against water contamination, helping to identify potential health threats early and ensuring that appropriate actions are taken to keep everyone safe. By understanding these processes, you become more aware of the importance of water safety and what steps are necessary to protect yourself and your community.

Varify 17in1 Complete Drinking Water Test Kit - 100 Strips + 2 Bacteria Tester Kits - Well, Tap, Home, City Water Testing Strip for Lead, Alkaline, Chlorine, Hardness, Iron, Fluoride, Copper & More
17 IMPORTANT PARAMETERS: The Varify Premium Drinking Water Test Kit offers an unrivaled, complete analysis of your drinking...
As an affiliate, we earn on qualifying purchases.
Frequently Asked Questions
How Often Should I Test My Water for Bacteria?
You should test your water for bacteria at least once a year to guarantee water safety planning is effective. If you notice any changes in taste, smell, or appearance, test more frequently. Well water users need to test more often, especially after storms or repairs. Regular testing helps catch contamination early, giving you peace of mind and protecting your health. Stay proactive by scheduling testing consistently and adjusting based on your water source.
Can Bacteria Tests Detect All Harmful Microbes?
Bacteria tests can’t detect all harmful microbes because of microbial diversity and testing limitations. Some microbes may not grow in standard tests or require specific conditions to be identified. While these tests are useful for common bacteria like coliform and E. coli, they may miss others that pose health risks. To guarantee safety, consider thorough testing and consult with experts if you suspect other microbial contamination.
What Are the Costs Associated With Bacteria Testing?
You might be surprised how much bacteria testing costs—ranging from $20 at home to over $300 in a lab. The key is testing accuracy; lab tests are more precise but pricier, while home kits are affordable but less reliable. If you want peace of mind, investing in professional testing guarantees you get accurate results, even if it costs a bit more. Don’t compromise your health—choose wisely.
How Long Does It Take to Get Test Results?
You’ll typically get your test results within 24 to 48 hours after sample collection, depending on the laboratory’s process. During this time, they focus on testing accuracy to guarantee reliable results. Prompt sample collection is vital because delays can affect accuracy. Once tested, you’ll receive clear results that help you understand your water quality and decide on necessary next steps to ensure safety.
Are Home Testing Kits Reliable Compared to Lab Tests?
Did you know that DIY testing kits have about a 70% accuracy rate? While convenient, they often lack the precision of lab tests. For reliable results, it’s best to seek professional validation, especially for critical health decisions. Home kits can give you a good initial indication, but lab testing guarantees accuracy and peace of mind. Trust lab results for definitive information on bacteria presence in your water.

23-in-1 Drinking Water Test Kit for Home, 155 Water Test Strips for Tap & Well Water, Tests Hardness, Lead, Iron, Copper, Chlorine, Fluoride, pH, Nitrate & More
23-IN-1 COMPREHENSIVE WATER SCREENING – Test key drinking water indicators including hardness, pH, lead, iron, copper, chlorine, fluoride,...
As an affiliate, we earn on qualifying purchases.
Conclusion
Now that you understand bacteria tests like coliform and E. coli, you’re better equipped to protect your water quality. Did you know that over 20% of tested water sources show some level of contamination? Regular testing and prompt action can make a huge difference in keeping your family safe. Stay vigilant, follow recommended procedures, and don’t hesitate to seek professional help if tests come back positive. Your health depends on it.

21-in-1 Home Drinking Water Testing Kit,145 Strips + 4 Bacteria Tests,Tap and Well Water Test Kit, Easy to Test and Read Home Test Strips for Hardness, Lead, Iron, Fluoride, pH, Copper and More
21-in-1 Home Drinking Water Testing Kit: Professional-grade test strips deliver accurate results for critical parameters in a short...
As an affiliate, we earn on qualifying purchases.

Umlecoa 16 in 1 Premium Water Test Kit - 125 Home Water Quality Test Strips for Well and Tap Test Kit - Testing for pH, Hardness, Chlorine, Lead, Iron, Copper, Nitrate, Nitrite, etc
🌍 【16-in-1 Water Test Kit】- With Umlecoa water quality test kit, you may know level of Water Hardness,...
As an affiliate, we earn on qualifying purchases.









